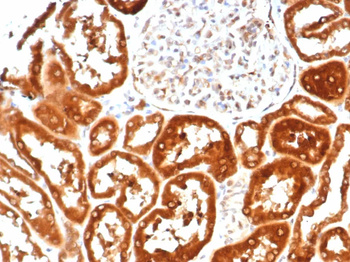
IL-6 (Interleukin-6) / Interferon beta-2 (Hybridoma Growth Factor) Antibody

You have no items in your shopping cart.
Search results for: 'IL-6'
IHC
Human
Mouse
Monoclonal
Unconjugated
100 μg, 100 μg (without BSA and Azide), 20 μgIHC
Human
Mouse
Monoclonal
Unconjugated
100 μg, 100 μg (without BSA and Azide), 20 μgIHC
Canine, Equine, Feline, Human
Mouse
Monoclonal
Unconjugated
100 μg (without BSA and Azide), 100 μg, 20 μgIHC, WB
Human
Mouse
Monoclonal
Unconjugated
100 μg (without BSA and Azide), 100 μg, 20 μg- PARP/PARP1 Antibody (monoclonal, 10E11) [orb738401]
FC, ICC, IF, IHC, WB
Human, Mouse, Rat
Mouse
Monoclonal
Unconjugated
100 μg - Human IL6 protein (Active) [orb358972]Featured
Active> 96% as determined by SDS-PAGE and HPLC.
20.7 kDa
E.Coli
5 μg, 500 μg, 100 μg - Monkey IL6 protein (Active) [orb358999]Featured
Active> 97% as determined by SDS-PAGE and HPLC.
21.1 kDa
E.Coli
100 μg, 10 μg, 500 μg - Mouse IL6 protein (Active) [orb359012]Featured
Active> 97% as determined by SDS-PAGE and HPLC.
21.7 kDa
E.Coli
100 μg, 500 μg, 10 μg